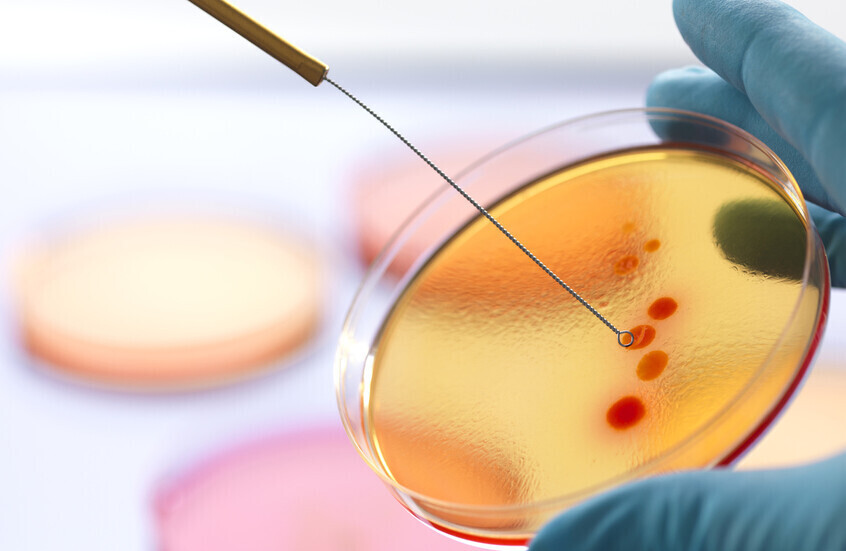

بكتيريا تساعد – صحة
أفادت دراسة أسترالية أن البكتيريا التي تنتقل بين الأشخاص أثناء العلاقة الحميمة يمكن استخدامها في الاختبارات الجنائية.
وذلك للمساعدة في التعرف على مرتكبي الاعتداءات الجنسية.
ووجد الباحثون أن البكتيريا التناسلية، المشابهة للكائنات الدقيقة التي تشكل ميكروبيوم الأمعاء، تختلف بين الأفراد.
وتنتقل هذه البكتيريا بين الأشخاص أثناء العلاقة الجنسية وتترك بصمات محددة يمكن اكتشافها لاحقا.
الدكتور بريندان تشابمان
وقال الدكتور بريندان تشابمان، المشرف الرئيسي على الدراسة من جامعة مردوخ، إن تقنية تتبع الميكروبيوم الجنسي للفرد، أو ما أطلق عليه الباحثون “السيكسوم” (Sexome)، يمكن أن تستخدم في النهاية في حالات الاعتداء الجنسي حيث لا يتم اكتشاف الحيوانات المنوية.
ويوضح تشابمان: “إذا لم يكن هناك قذف، أو تم استخدام وسيلة منع حمل حاجزة، أو إذا كان الرجل قد خضع لعملية قطع القناة المنوية..
فهنا تبرز أهمية هذه التقنية كنهج بديل محتمل”.
بكتيريا rRNA
وركز الباحثون على جين بكتيري يعرف باسم 16S rRNA، غير موجود في البشر.
ويختلف التسلسل الجيني لهذا الجين في البكتيريا الموجودة لدى أشخاص مختلفين.
وأظهرت مسحات تناسلية مأخوذة من 12 ثنائيا (أي 24 شخصا) قبل وبعد الجماع أن البصمة البكتيرية للشخص يمكن تحديدها على شريكه بعد العلاقة الجنسية.
كما لوحظ أن هذه البصمة تنتقل حتى عند استخدام الواقي الذكري،
رغم أن معظم الانتقال في هذه الحالات كان من الأنثى إلى الذكر. ومع ذلك،
أشار تشابمان إلى وجود عوامل غير معروفة مثل توقيت استخدام الواقي أثناء العلاقة.
البصمة البكتيرية
وفي أحد الأزواج، بدا أن البصمة البكتيرية استمرت لمدة خمسة أيام بعد انتقالها بين الشريكين، وفقا لتشابمان.
واقترح الباحثون أن هذه التقنية يمكن أن تزيد من الفترة الزمنية المتاحة لإجراء الفحوصات بعد الاعتداء الجنسي “بما يتجاوز ما هو ممكن حاليا” باستخدام تحليل الحمض النووي التقليدي،
حيث تكون احتمالية اكتشاف الحيوانات المنوية أعلى في أول 24 ساعة بعد الاعتداء.
ومع ذلك، قال تشابمان إن التقنية “ما زالت بحاجة إلى وقت قبل أن تستخدم في المحكمة”،
مشيرا إلى الحاجة لتحسين دقة البصمات البكتيرية التي يمكن اكتشافها.
كما يأمل الفريق البحثي في فهم أفضل لـ”السيكسوم” في غياب الجماع، وكيف يتغير خلال الدورة الشهرية للأنثى.
البروفيسور دينيس ماكنفين
ومن جهته، قال البروفيسور دينيس ماكنفين، أستاذ علم الوراثة الجنائية في جامعة التكنولوجيا في سيدني، الذي ولم يشارك في الدراسة،
إن تحليل البصمة الجينية البكتيرية يمكن استخدامه لتأييد أو معارضة الشهادات في قضايا الاعتداء الجنسي المزعومة
حيث تكون أدلة الحمض النووي الأخرى ناقصة أو غير كافية.
وأضاف: “سيظل الحمض النووي هو الخيار الأول دائما”،
واصفا تتبع البكتيريا بأنه “ملاذ أخير لأنه يتطلب وقتا أطول، وهو أكثر تكلفة – إنه تحليل متخصص”.